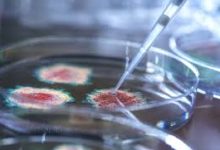

لأول مرة في رمضان.. الأذان يرفع في ملعب أولد ترافورد التابع لمانشستر يونايتد
حول مانشستر يونايتد ملعب أولد ترافورد إلى أكثر من مجرد ملعب لكرة القدم هذا الأسبوع، فبالتعاون مع نادي مشجعيهم المسلمين،…
د. محمد حسن معاذ خلال كلمته بندوة مؤسسة رسالة السلام: لفظ الرحمة ومشتقاته ورد في القرآن (322) مرة مما يعكس مركزية هذا المفهوم في الخطاب القرآني
شارك الدكتور محمد حسن معاذ الأستاذ المساعد بجامعة مترو الحكومية – إندونيسيا دكتوراه في الفلسفة الإسلامية في ندوة مؤسسة رسالة…
للحصول عليه, شروط وخطوات الحصول على معاش ربة المنزل 2026 والأوراق المطلوبة
تبحث الكثير من ربات البيوت،عن كيفية الحصول علي معاش ربات البيوت وفقاً لأحكام قانون التأمينات الاجتماعية والمعاشات رقم 148 لسنة…
بالرابط.. فتح باب التقديم على استمارة الثانوية العامة 2026 مرة أخرى للطلاب
استمارة الثانوية العامة 2026، من أكثر ما يبحث عنه طلاب الثانوية العامة الآن استعدادا لدخول الامتحان النهائي للعام الدراسي 2025\2026،…
نص كلمة الكاتب والمفكر الاستاذ على الشرفاء أمام ندوة “شهر رمضان الذى انزل فيه القران”: ليلة القدر بين العمل بالقرآن والهجران
فى بداية ندوة “شهر رمضان الذى انزل فيه القرآن”التى نظمتها مؤسسة رسالة السلام وسط حضور حاشد ..قام الاعلامى مجدى طنطاوى…
على محمد الشرفاء يكتب: القرآن يؤسس لحياة سعيدة للإنسان
لنتخذ القرآن كما أراد الله مرجعا لكل أعمال الصالحات والعبادات ، ومتى نسمع أو نقرأ شيئا يتحدث أو يفتي في…
تفاعل واسع مع كلمة علي الشرفاء في ندوة ” شهر رمضان الذي أنزل فيه القرآن “
في أجواء إيمانية وفكرية مميزة، شهدت ندوة مؤسسة رسالة السلام حول ” شهر رمضان الذي أنزل فيه القرآن ” تفاعل…
في ندوة «رسالة السلام».. مشيرة خطاب : نصر أكتوبر أعاد الكرامة ورسّخ قيم العدالة | صور
في إطار المشروع الفكري للمفكر العربي علي الشرفاء الحمادي الداعي إلى العودة إلى القرآن الكريم باعتباره المرجعية الأولى في بناء…
علي محمد الشرفاء يكتب: موقف زايد القائد فى حرب العاشر من رمضان
الشيخ زايد رحمه الله هو الذي بادر كأول رئيس دولة عربية اتخذت قرار قطع البترول عن أمريكا والغرب، وكنت أنا…
استبدال أحكام المادتين 5 و10.. تعرف على التعديلات الجديدة في قانون التصالح
قالت الإعلامية نيفين منصور، إنه في شهر يناير الماضي أصدر رئيس الوزراء الدكتور مصطفى مدبولي القرار رقم 36 لسنة 2026،…